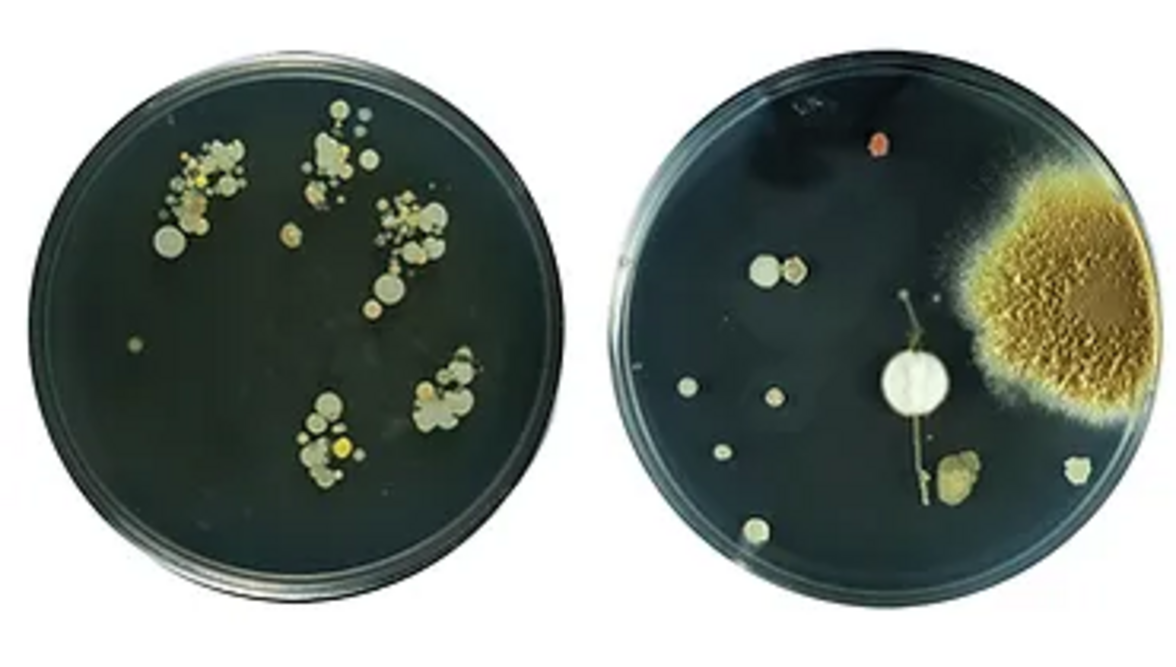
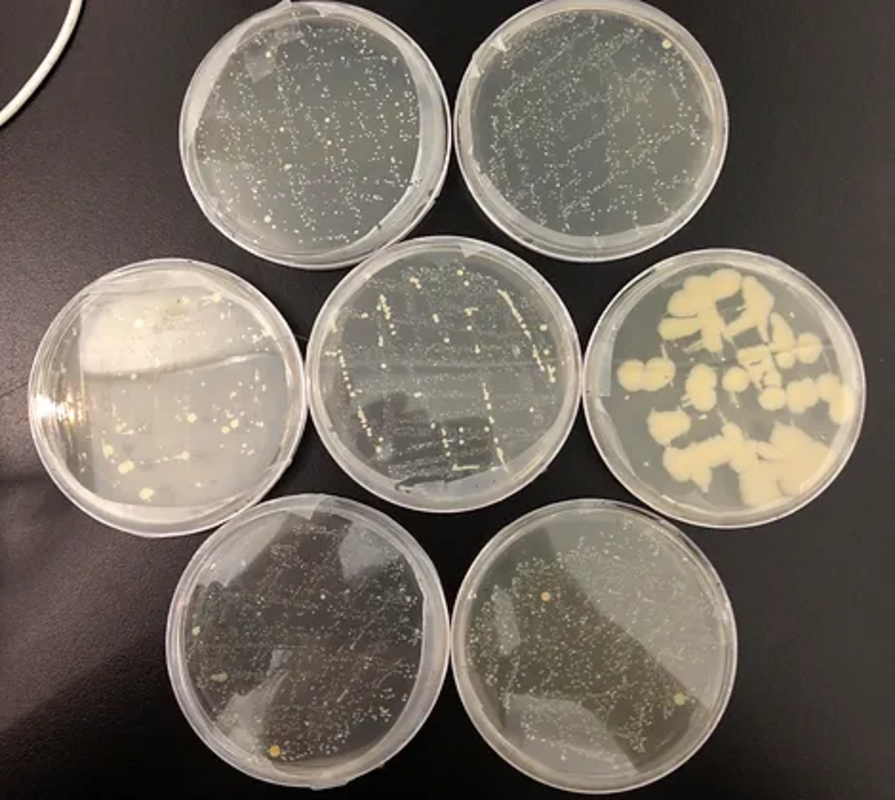
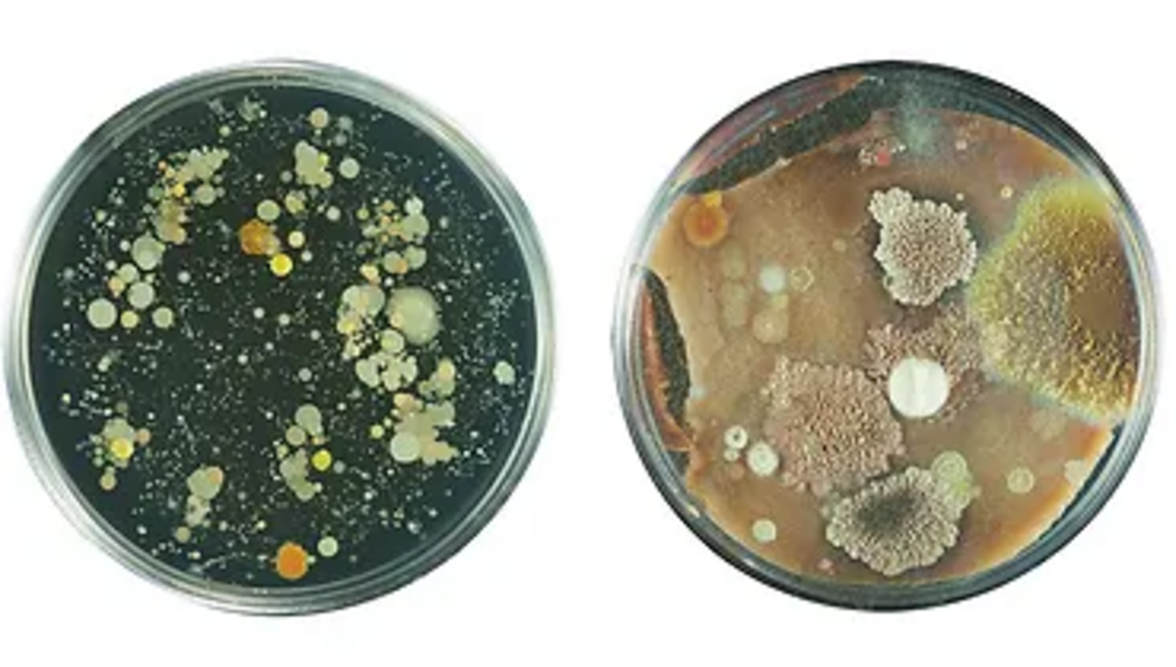

Я португалка, но уже 13 лет живу в США и мой интерес, как художника сосредоточен не на сборе данных, а на создании работ, которые помогают мне понять, что такое микробиом: как большая часть нашего мира невидима, как большая часть нас самих невидима, и как микробиом напрямую, онтологически, связывает каждого из нас с окружающей средой.
Мы состоим из многих вещей, большинство из них живые, но не люди. Наши человеческие и нечеловеческие "я" сосуществуют, сотрудничают, конкурируют или игнорируют друг друга. В этой серии работ я исследую микробиом человека как еще одно "я" или как множество других "я". Понятие о том, что в нашем организме есть бактерии, не является чем-то необычным, хотя обычно оно связано с теми, кто вызывает у нас заболевания, и с теми, кто живет в нашем кишечнике и помогает переваривать пищу. Многие из них играют важную роль в нашем здоровье и самочувствии, и пока неясно, в какой степени они влияют на наше самочувствие и в какой степени они - это тоже мы.
Но теперь мы знаем несколько важных фактов: в теле человека нечеловеческих клеток в 10 раз больше, чем человеческих, и более чем в 100 раз больше нечеловеческой ДНК, чем человеческой.
Изначально меня заинтересовали две идеи: во-первых, что человеческий организм - это чрезвычайно богатая среда, в которой в разных местах существуют совершенно разные популяции микроорганизмов, и, во-вторых, что микробиом в целом формируется из окружающей нас среды. Последнее, в частности, имело огромный смысл: наши "попутчики" должны были происходить в первую очередь из воздуха, которым мы дышим, пищи, которую мы едим, и пространства, в котором мы перемещаемся.
Первым делом были взяты мазки с различных частей моего тела (головы, лица, рук) и окружающей среды (стол, воздух, ручка двери в комнату, мобильный телефон). Мазки были посеяны на чашки Петри (LB-агар) и оставлены расти в инкубаторе без вмешательства (37 градусов). Первый набор посевов был довольно интересным. Я не мыла руки несколько часов, прежде чем прикоснулась кончиками пальцев к чашке. Другая чашка справа была оставлена открытой во время отбора проб и служила одновременно для посева окружающего воздуха и контролем.
Слева: отпечатки моих пальцев; справа: "воздушный отпечаток".
Затем были сделаны посевы (отпечатки) с различных частей головы (волосистая часть головы, брови, нос, щеки, подбородок):
и на основе снимков выросших микроорганизмов была сделана цифровая композиция, в которой все чашки с "отпечатками" человека были объединены вместе в "автопортрет", и то же самое было сделано для всех чашек с "отпечатками" окружающей среды. В результате я сделала два вывода: хотя в целом "человеческие" чашки демонстрируют интересное для нетренированного глаза разнообразие, сложно различить отпечатки из разных частей тела. Скорее всего, это связано как с ограничениями методики (очень трудно воспроизвести богатые и разнообразные условия человеческой кожи с помощью одной и той же питательной среды), так и с ограничениями навыков "бактериолога" (т.е. меня).
Слева: автопортрет; справа: "автопортрет" окружающей среды
Второй вывод: несмотря на богатый рост, между чашками, полученными от человека и из окружающей среды, действительно очень мало совпадений. Известно, что условия in vitro не способствуют росту естественного разнообразия микробиома кожи, и на некоторых чашках была видна молочная биопленка без каких-либо цветов и текстур отдельных выросших колоний:

Красивые и тонкие границы возникли в результате сложных взаимодействий, обусловленных физическими, химическими и биологическими напряжениями, создаваемыми микробами. С помощью мощной камеры были обнаружены удивительные организмы, образующие странный, инопланетный пейзаж:

Я связалась с несколькими лабораториями, специализирующимися на изучении микробиома, чтобы получить комментарии по моей работе, и они подтвердили, что мои результаты совпадают с тем, что происходит в научных исследованиях: в нескольких крупных работах подтверждается, что микробиом действительно формируется в основном не из окружающей среды, а от наших матерей. Мы наследуем его при прохождении через родовой канал.
В конце концов, это не связь между человеком и миром, а между человеком и человеком или, лучше сказать, между матерью и ребенком. Мы частично принадлежим не своему миру, а своим матерям.
